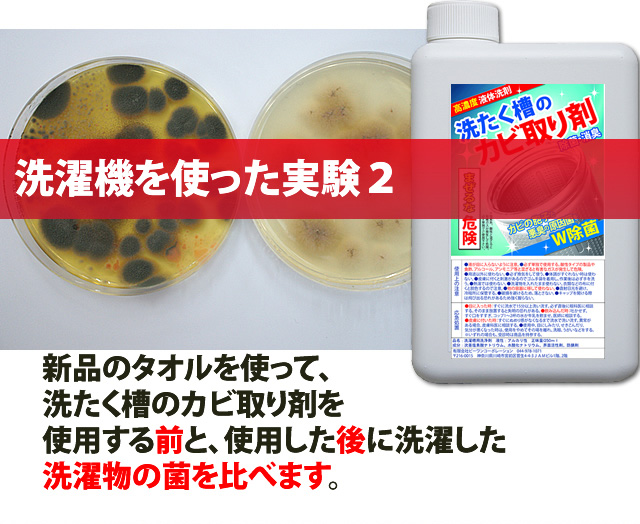

洗濯槽クリーナー 1,000ml 4回分(約半年) 柔軟剤が香る♪ 洗たく槽のカビ取り剤 ドラム式もOK カビを99.9% 除菌 消臭(03)
(7件)
メーカー希望小売価格: 1,598円
1,598円(税込)
0ポイント(1%)
商品説明
| 商品詳細 | |
| 内容 | 洗たく槽のカビ取り剤(塩素系) 1,000ml |
| 用途 | 洗濯槽のクリーナー(プラス消臭効果) ・洗濯槽内部のカビ取り ・洗濯槽内部のバクテリアの除菌 |
| 成分 | 次亜塩素酸ナトリウム 水酸化ナトリウム 界面活性剤 珪酸ナトリウム(防錆剤) ※独自の配合により、カビが良く取れ、洗剤カスや皮脂カスを剥離し除菌する |
| 使用量目安 | 9キロまでの洗濯機に対し、本剤250mlを使用してください。 40℃のぬるま湯で使用すると効果UP 6〜10時間程度つけ置くと、より効果的です。 |
| 使用頻度 | 1〜2か月に1度ご使用ください。 初めてご使用になる、また汚れがひどい場合は1回で500ml投入し、約6〜10時間つけおいてください。 |
| 使用期限 | 1年間(お早目にご使用ください) |
| こちらもおすすめ | カビ取り剤のシリーズ一覧はこちら |

| ビーワンショップのカビ取り剤シリーズ | |
|
|
|
|
|
|
|
|
カビ取りプロ歴35年が作った高濃度塩素の洗濯槽クリーナー。液体タイプなのでドラム式の洗濯機にも使えます。粉末タイプの洗濯槽クリーナーでは除菌できないカビの胞子も、高濃度塩素が99.9%除菌。(衛生微生物研究センターでガラスプレートによる試験済み)。部屋干しでも柔軟剤がしっかり香ります。1,000ml入って4回分。1-2ヶ月おきに使用してください。洗濯槽に水を溜めて(高水位)、洗濯槽クリーナーを250ml投入。*半年以上、洗濯槽クリーナーを使用していなかった場合は500ml投入。5分程度洗いをして電源を切り6-10時間程度放置して、すすぎ、脱水してください。ドラム式の場合は 、洗濯槽に薬剤を直接投入し、洗いの時間を最長に設定し、つけ置かずにすすぎと脱水をして終了です。槽洗浄機能が付いている場合は利用してください。40度程度のぬるま湯を使用すると、より効果的です。
レビュー
- まあまあです。
- 1回250mLですが、1000mL入ってるので、直接入れると量が難しいです。あと、容器に液が垂れるので、手などに付かないよう気を付けましょう。 きれいになったかどうかはわかりませんが、使わないよりはいいのかなと思います。成分名しか書いてないので、他のメーカーとの違いがわからず、良い商品かどうかは不明です。 しかし、次亜塩素酸ナトリウムの製品は、時間経過で濃度が低下すると聞いたことがあるので、1回分ずつ小分けになってるほうが良いのではないかと思いました。次からは小分けのものを買います。
- いいと思います!
- 普段から洗濯機の洗濯槽洗浄機能で洗浄しているので、そんなに汚れてはいないと思ったら、つけおきの水が結構汚れてました。 みなさんのレビューを見て購入して良かったと思います。
- 匂いがなくなった
- 黒いあくが出ないが匂いがなくなった。お値段は高いが掃除しやすいのが便利!
- やらないより良いのかな
- 洗濯槽ギリギリまでぬる湯をはり、半分の量を入れ一晩置いてから全自動スイッチON。正直効果があったのかはわかりません。でもやらないより良いのかなと思うので、定期的に使用しようと思います。
- スッキリ
- 安いクリーナーと違って使用後の汚れカスが出ないのでとてもいいです。本当にキレイになっているのか心配でしたが、周りのゴムパッキン?までキレイになっているので中もキレイになっているはず。
すべてのレビューを見る
















